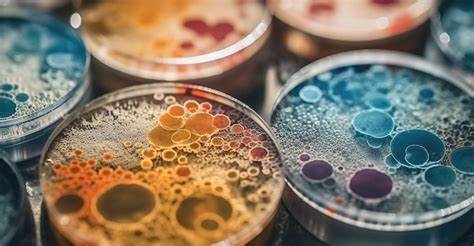

Pourquoi les épidémies de peste ont-elles duré si longtemps ? La lèpre existait-elle déjà en Amérique avant l’arrivée des Européens ? Pour répondre à ces deux grandes questions, des chercheurs ont mené un véritable travail d’archéologie microbienne, analysant des bactéries parfois vieilles de plusieurs millénaires.
Deux études sur l’histoire de ces maladies emblématiques viennent d’être publiées par la revue Science, apportant un éclairage nouveau sur la peste, tristement célèbre pour la Peste noire, et sur la lèpre, longtemps synonyme de stigmatisation. « La bactérie de la peste a une importance particulière dans l’histoire de l’humanité. Il est donc essentiel de comprendre comment ces épidémies se sont propagées », explique à l’AFP le microbiologiste Javier Pizarro-Cerda, co-auteur de la première étude. Le chercheur travaille à l’Institut Pasteur, qui a pris part aux deux publications, en collaboration notamment avec l’Université canadienne McMaster. Cette première étude se penche sur la longévité des épidémies de peste à travers les siècles. Depuis deux mille ans, l’humanité a connu trois grandes pandémies : La peste de Justinien, qui a marqué pendant deux siècles la fin de l’Antiquité ; La deuxième pandémie, initiée par la Peste noire au XIVe siècle, qui a décimé près de la moitié de la population européenne et donné lieu à des résurgences pendant des centaines d’années ; La troisième pandémie, née en Asie au XIXe siècle et toujours active aujourd’hui, avec des cas réguliers en Afrique subsaharienne, notamment en République démocratique du Congo, à Madagascar ou en Ouganda. Les scientifiques ont analysé des échantillons de la bactérie Yersinia pestis, responsable de la peste bubonique, correspondant à chacune de ces vagues épidémiques. Un point commun est ressorti : dans les trois cas, la bactérie a subi une évolution génétique tendant à réduire progressivement sa virulence. Contrairement à ce que l’on pourrait penser, ce n’est pas la baisse de dangerosité du microbe qui a permis d’éradiquer les épidémies. Au contraire, en devenant moins agressive, la bactérie a provoqué des infections plus modérées, mais plus longues, lui donnant davantage d’occasions de se transmettre d’une personne à l’autre. En infectant des groupes de rats avec des souches anciennes et récentes, les chercheurs ont confirmé cette hypothèse : lorsque la virulence de la bactérie diminue, la maladie dure plus longtemps. Cette découverte change profondément la compréhension des dynamiques épidémiques passées. « Cela nous permet de mieux saisir la façon dont les agents pathogènes s’adaptent à leur environnement, et nous aide à réfléchir à des stratégies de défense plus efficaces », souligne M. Pizarro-Cerda. Si les antibiotiques d’aujourd’hui permettent de contrôler la maladie, cette étude éclaire les mécanismes naturels d’adaptation des microbes. La seconde étude, également coordonnée par l’Institut Pasteur en partenariat avec l’Université du Colorado, explore la trajectoire historique de la lèpre sur le continent américain. En analysant des centaines d’échantillons archéologiques provenant d’Amérique du Nord et du Sud, les chercheurs ont retrouvé des traces de Mycobacterium lepromatosis, une des deux bactéries connues responsables de la lèpre. Or, ces traces datent d’il y a environ 9 000 ans, bien avant l’arrivée des colons européens. « On montre qu’il existait déjà une forme de lèpre sur le continent américain, répandue à large échelle », explique Nicolas Rascovan, paléogénomiste à l’Institut Pasteur et co-auteur de l’étude. Contrairement à ce que l’on croyait, la lèpre n’a donc pas été exclusivement importée par les Européens, même si ces derniers ont bien introduit une autre souche, Mycobacterium leprae, autrefois considérée comme l’unique agent de la maladie. Cette révélation modifie le regard porté sur la propagation historique de la lèpre et ouvre de nouvelles perspectives de recherche. « Il nous reste encore une grande diversité à découvrir concernant Mycobacterium lepromatosis. Et nous savons désormais que c’est en Amérique qu’il faut poursuivre les investigations », conclut M. Rascovan. Ces travaux offrent une meilleure compréhension de l’histoire de deux grandes maladies infectieuses, tout en apportant des clés précieuses pour anticiper et gérer les pandémies d’aujourd’hui et de demain.
Neila M